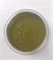

Паста фисташковая Diamante Pistacchio Verde, 250г
Паста фисташковая Diamante Pistacchio Verde, 250г
Есть в наличии
Вес
0
кг.
Ед. измерения
Штука